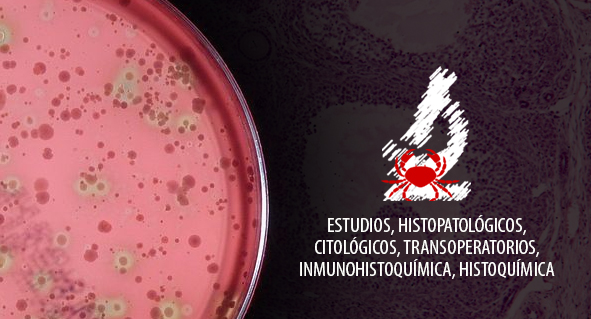
image description

PHATOLOGY LAB CQ
Servicios de estudios, histopatológicos, citológicos, transoperatorios, inmunohistoquímica, histoquímica
TORRE DE ESPECIALIDADES ÁNGELES DEL CARMEN
Pontevedra 2446
Col. Santa Elena Estadio,
Guadalajara, Jalisco.

Pontevedra 2446
Col. Santa Elena Estadio,
Guadalajara, Jalisco.
 3338236275
3338236275